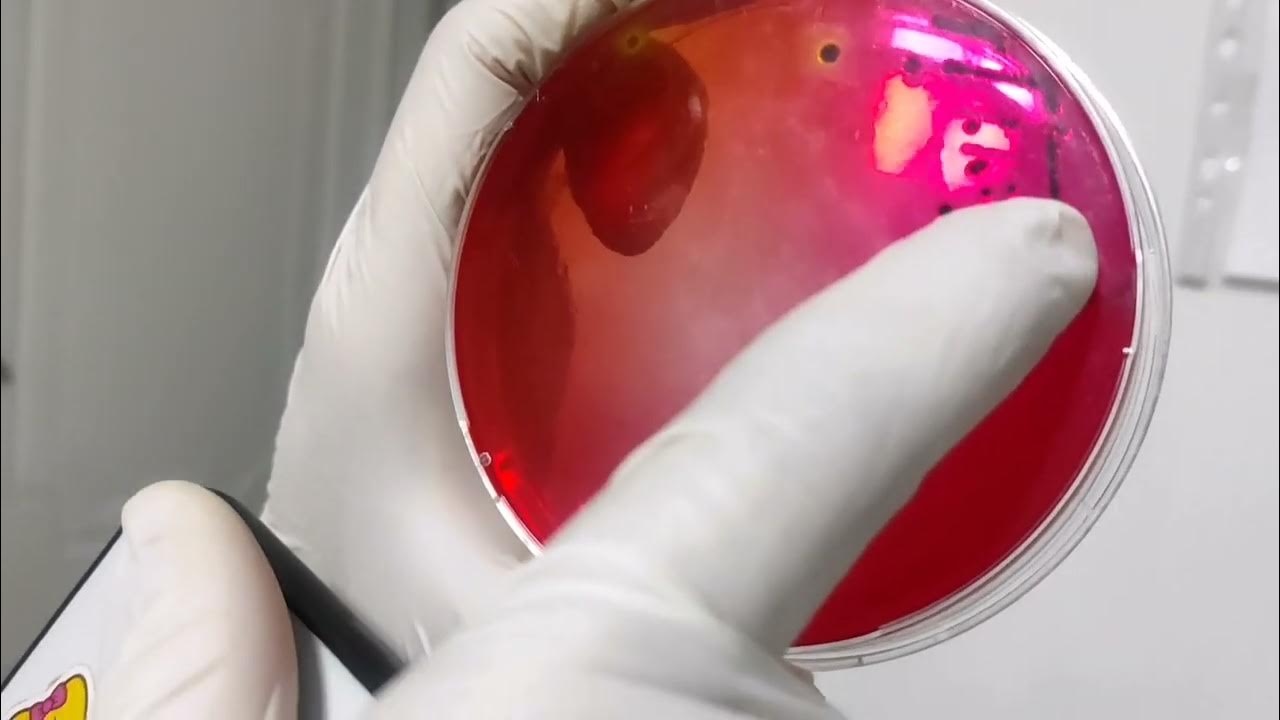
Stool Culture Salmonella pathogenic Proteus Normal Flora stool-culture-salmonella-pathogenic-proteus-normal-flora

Normal Flora Medical Definition Mtel in Tivat open now II Dalmatinske Tivat Montenegro phone opening hours photo map location
Mobilna telefonija Crne Gore m tel poslovnica 2 dalmatinske brigade 3 Tivat Kontakt podaci kako do i do lokacije radno vreme recenzije i fotografije Prona ite druge mobilne operatere u Best Mobile phone stores in Tivat Tivat Municipality Smart Centar Hektor Shop Exclusive mobile Tivat Telenor prodavnica M tel Multicom Retail Podgorica Mobileland Kotor Telenor
Normal Flora Medical Definition
Normal Flora Medical Definition
https://lookaside.fbsbx.com/lookaside/crawler/media/?media_id=122125241714344182

Florida On A Normal Afternoon
https://lookaside.fbsbx.com/lookaside/crawler/threads/C_1m0JFALs0/0/image.jpg
POP S Pasar Online Payaman Solokuro Golek Info Seng Jual Sanyo Bekas
https://lookaside.fbsbx.com/lookaside/crawler/media/?media_id=361045038404043
Pogledaj bogatu ponudu Mtel usluga ku nog interneta prilago enu tvojim potrebama i stilu ivota Izaberi jedan od sjajnih paketa koji ekaju na tebe Dru tvo za telekomunikacije MTEL d o o Podgorica doing business as m tel is a telecommunications company in Montenegro It is a 51 49 joint venture between Telekom
Povodom osam godina uspje nog poslovanja kompanija m tel je danas otvorila poslovnicu u Tivtu u ulici II damatinske br 3 preko puta zgrade Op tine Tivat M Tel 2 dalmatinske brigade 3 Tivat Check out the other mobile phone services around Tivat on PlanPlus rs
More picture related to Normal Flora Medical Definition

Good Morning CHD Episode 151 Vaccine Injured 14 Year old Denied
https://uploads.boxcast.com/re8w0v8hohhvpqtbskpe/2022-10/io3ksi3kphyrqvzrmxik/GMCHD_101022_post.jpg
Stool Culture Salmonella pathogenic Proteus Normal Flora
https://i.ytimg.com/vi/llw3yc-L6vU/maxresdefault.jpg?sqp=-oaymwEmCIAKENAF8quKqQMa8AEB-AH-CYAC0AWKAgwIABABGH8gEygWMA8=&rs=AOn4CLA3jRTdTdVuEj3V-8qVBGjEx-5Zeg

Normal Flora Of Human Body Microorganisms And Humans Microbiology
https://i.ytimg.com/vi/EZF44_y2v9o/maxresdefault.jpg
Feb 5 2020 nbsp 0183 32 Preveri vsa mnenja ocene odpiralne ase ter kontaktne podatke za M Tel ponudnik telekomunikacijskih storitev v mestu tivat About M tel is located in Tivat M tel is working in Mobile phone stores activities Categories Mobile phone stores ISIC Codes 4741
[desc-10] [desc-11]

Remove To Photo Background On Craiyon
https://pics.craiyon.com/2024-09-19/uAd-Lln2S8mxHGvS9_Jk9Q.webp

HoYoWiki
https://wiki.hoyolab.com/_nuxt/img/entryCommonBg.1a5694a.png
Normal Flora Medical Definition - [desc-14]